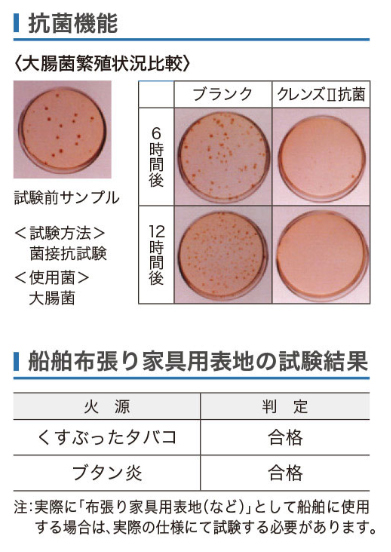
抗菌機能、船舶布張り家具用表地の試験結果

【多機能レザートップ】
張地の機能説明
- 〈準耐アルコール〉
- まれにこぼすお酒や、年に数回程度のアルコールメンテナンスであれば商品寿命が縮む心配はありません。
- 〈耐次亜塩素酸〉
- 消毒に使用される次亜塩素酸の漂白効果により、色が抜ける現象を軽減します。
※必要以上の高濃度でレザーを拭いてしまうと色が落ちます。 - 〈防汚〉
- 汚れが付きにくく、落としやすい加工を施してあります。
- 〈Ag系抗菌〉
- 銀系の抗菌剤を練りこんだタイプで抗菌作用があります。
- 〈船舶難燃〉
- 燃えにくい素材です。JABIA規格 V-1330取得。
- 〈難燃〉
- 日本自動車車体工業会の難燃試験に合格した商品でJIS L 1091と同等の難燃合格品です。
多機能レザー クレンズⅡ
※画像は実物と見え方が異なる場合がございます。
※()内の数字は旧品番です。
クレンズⅡ
- サイズ:
- 122cm×30cm 乱
- 裏地:
- メリヤス
- 機能:
- 準耐アルコール、耐次亜塩素酸、防汚、Ag系抗菌、船舶難燃、難燃

クレンズⅡ 張地の機能説明
- 〈防汚〉
- 汚れが付きにくく、落としやすい加工を施してあります。
- 〈準耐アルコール〉
- まれにこぼすお酒や、年に数回程度のアルコールメンテナンスであれば商品寿命が縮む心配はありません。
- 〈耐次亜塩素酸〉
- 消毒に使用される次亜塩素酸の漂白効果により、色が抜ける現象を軽減します。
※必要以上の高濃度でレザーを拭いてしまうと色が落ちます。 - 〈船舶難燃〉
- 燃えにくい素材です。JABIA規格 V-1330取得。
- 〈Ag系抗菌〉
- 銀系の抗菌剤を練りこんだタイプで抗菌作用があります。
- 〈難燃〉
- 日本自動車車体工業会の難燃試験に合格した商品でJIS L 1091と同等の難燃合格品です。
クレンズⅡ 張地の機能詳細